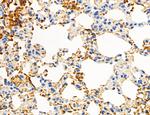
Phospho-Axl (Tyr702) Antibody in Immunohistochemistry (Paraffin) (IHC (P))

Search
Invitrogen
Phospho-Axl (Tyr702) Polyclonal Antibody
{{$productOrderCtrl.translations['antibody.pdp.commerceCard.promotion.promotions']}}
{{$productOrderCtrl.translations['antibody.pdp.commerceCard.promotion.viewpromo']}}
{{$productOrderCtrl.translations['antibody.pdp.commerceCard.promotion.promocode']}}: {{promo.promoCode}} {{promo.promoTitle}} {{promo.promoDescription}}. {{$productOrderCtrl.translations['antibody.pdp.commerceCard.promotion.learnmore']}}
图: 1 / 6
Phospho-Axl (Tyr702) Antibody (PA5-106218) in IHC (P)

Please note: We are reviewing Western blot images included in the antibody testing data in our catalog, including those provided by third parties. Unless expressly labeled or annotated as “raw-unedited”, Western blot images included in the antibody testing data in our catalog may have been edited, optimized or otherwise adjusted for presentation.
产品信息
PA5-106218
种属反应
宿主/亚型
分类
类型
抗原
偶联物
形式
浓度
规格
纯化类型
保存液
内含物
保存条件
运输条件
RRID
产品详细信息
Antibody detects endogenous levels of AXL only when phosphorylated at Tyr702.
靶标信息
AXL is a chronic myelogenous leukemia-associated oncogene that is also associated with colon cancer and melanoma. The AXL protein is a receptor tyrosine kinase that transduces signals from the extracellular matrix into the cytoplasm by binding growth factors like vitamin K-dependent protein growth-arrest-specific gene 6, and is involved in the stimulation of cell proliferation. TAM receptors are also involved in phagocytosis of apoptotic cells. Mice lacking all three TAM receptors have several degenerative phenotypes linked to inefficient removal of apoptotic cells and membranes (e.g., in the retina and the male reproductive tract) and develop a severe autoimmune phenotype akin to systemic lupus erythematosus, including the production of broad spectrum auto-antibodies. In addition, Axl may function as a putative entry receptor for filoviruses. Axl is also used to identify a specific subpopulation of human blood dendritic cells, also referred to as Siglec 6+/Axl+ dendritic cells. Cellular expression of Axl can be upregulated by TLR ligands, such as LPS or poly I:C. Soluble Axl is generated by proteolytic cleavage of the membrane form. Increased plasma levels may be indicative of inflammation and cancer.
仅用于科研。不用于诊断过程。未经明确授权不得转售。
篇参考文献 (0)
生物信息学
蛋白别名: Adhesion-related kinase; AXL oncogene; AZF1; oncogene AXL; sAXL; soluble AXL; Tyrosine-protein kinase receptor UFO; ufo oncogene homolog
基因别名: AI323647; Ark; AXL; Tyro7; UFO
UniProt ID: (Mouse) Q00993
Entrez Gene ID: (Mouse) 26362, (Rat) 308444




